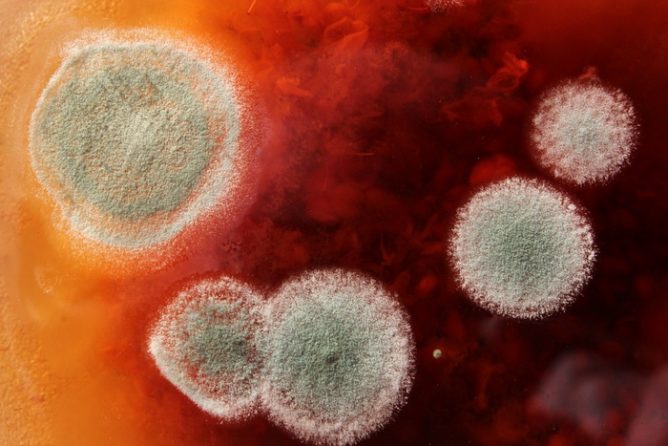
Грибок

Какие же причины плесени на окнах?
Версия для печати
Содержание статьи
Чтобы не пришлось искать средства, позволяющие избавиться от плесени на окнах из пластика, нужно знать правила их безопасной и эффективной эксплуатации. Соблюдение простых рекомендаций по обслуживанию конструкций станет лучшей мерой борьбы и профилактики появления проблемы — грибка на окнах, стенах и откосах. Если же предотвратить неприятное явление вовремя не вышло, нужно найти время для комплексной борьбы с микроорганизмами.
Причины образования плесени
Чаще всего плесень на пластиковых окнах появляется с наступлением отопительного сезона. Именно в этот период на откосах и подоконниках условия для образования и развития микроорганизмов становятся максимально благоприятными. С окончанием зимы, когда окна открывают для проветривания, воздух становится сухим и отключают отопительные приборы плесень исчезает без видимых усилий со стороны человека. Такой круговорот продолжается из года в год.

Основная причина появления плесени — точка росы. Разница температуры воздуха на улице и в помещении на поверхности стеклопакета, на подоконнике и откосах приводит к образованию конденсата. В свою очередь он преобразуется в воду, которая и становится приемлемой средой для развития грибка.
Кроме образования конденсата есть и другие причины появления плесени на окнах из пластика. Одна из них — негерметичные межпанельные швы. Обычно плесень на откосах по этой причине появляется спустя некоторое время после монтажа, в течение которого утеплитель активно собирает влагу.
В среднем, утеплитель вмещает в себя до 200 литров воды в зависимости от вида. Не имея возможности для испарения, вода находит выход — образует среду для развития грибка на откосах, подоконнике и стеклопакетах.
Не исключено, что плесень на откосах пластиковых окон является следствием некачественного монтажа конструкций. Если в процессе демонтажа старого окна проем не был должным образом очищен от грязи и обработан специальным фунгицидным средством, установка выполнялась в сырую погоду зимой или осенью, а щели не сочли нужным загерметизировать, рано или поздно о себе даст знать грибок.

Считается, что оптимальный уровень влажности в помещении — до 60%. Превышение этой отметки неизменно приведет к созданию подходящих для образования плесени на окнах условий. Поэтому до того, как искать средства и способы, позволяющие удалить плесень с окон, нужно подумать о поддержании условий, неблагоприятных для ее образования. К ним относятся:
- удаление дополнительных источников влаги;
- монтаж систем вентиляции;
- установка вытяжки;
- замена плотных портьер более легкими из «дышащих» материалов;
- постоянное проветривание для исключения образования конденсата;
- решение проблемы негерметичных швов.
Соблюдение простых рекомендаций выше позволит не допустить образования конденсата и грибка на окнах, который представляет серьезную опасность для здоровья.

Об опасности плесени: явные и скрытые риски
Появление плесени на окнах, откосах и подоконниках пластиковых конструкций нельзя оставлять без внимания.
Микроорганизмы представляют серьезную угрозу для здоровья и даже жизни. Четко осознавая, чем опасна плесень, нужно принимать меры, не допуская усугубления ситуации.
Грибок на пластиковых окнах способен стать причиной развития следующих болезней:
- кожных в виде разновидностей микозов и дерматозов, тяжело диагностируемых и сложно поддающихся лечению;
- дыхательных путей с преобразованием в хронические;
- опорно-двигательного аппарата;
- суставно-ревматического характера;
- мигрени;
- слабости;
- истощения.
Кроме того черная плесень может нести скрытую опасность, являясь серьезным аллергеном. Споры грибка при попадании в дыхательные пути способны вызывать острую аллергенную реакцию и вылиться в серьезную проблему, начиная от конъюнктивита и заканчивая респираторным аллергозом. В особенно запущенных случаях плесень в доме на окнах является главной причиной развития бронхиальной астмы.
Грибок на окнах — методы борьбы
Нужно понимать, что мало отмыть плесень на подоконнике и окнах, тщательно просушив конструкцию. Решением проблемы должен стать комплексный подход с устранением причин его появления и соблюдением мер профилактики в дальнейшем.
Процесс борьбы начинают с диагностики причины образования плесени на откосах, стеклопакетах и подоконниках. Чаще всего это несоблюдение температурного и влажностного режима в помещении и некачественный монтаж конструкции. Если в первом случае достаточно будет установить вентиляционные решетки, отрегулировать работу отопительных приборов и время от времени проветривать помещение, то во втором не обойтись без частичного демонтажа конструкции.

Начинают с удаления пластиковой отделку откоса и подоконника для зачистки от органических отложений. Следующий этап — просушивание поверхностей конструкции с использованием специальных воздухонагревателей или строительного фена. Чистое и сухое окно обрабатывают фингицидным средством, либо препаратом с содержанием хлора для борьбы с остатками плесени.
Имеющиеся щели аккуратно заделывают пеной, используя герметик для удаления мелких дефектов. Монтируют подоконник и откосы на прежнее место и наблюдают за эффектом в течение определенного времени. Если проведенные мероприятия по теплоизоляции не дали результата, в верхней части окна устанавливают дополнительные клапаны для улучшения вентиляции.

Слишком широкие подоконники, препятствующие распространению теплого воздуха, также могут быть причиной появления грибка на откосах пластиковых окон, стенах и стеклопакетах. В таком случае решением могут станут отверстия для дополнительной вентиляции непосредственно в конструкции подоконника или же направляющие теплый воздух от источника тепла к окну специальные решетки с жалюзи из пластика.
Эффективные средства для удаления плесени
Победить грибок на откосах можно только продуманным комплексным воздействием на проблему. Устраняя причины образования плесени, соблюдая меры профилактики его последующего образования, не стоит списывать со счетов и проверенные химические и народные средства, способные устранить следы имеющихся микроорганизмов.
Традиционно для удаления плесени пользуются медным купоросом. Применяют препарат, учитывая степень ядовитости с соблюдением мер безопасности, учитывая его коррозийные свойства, не допускающие контакта с металлом.

Хлорка, как уже было отмечено выше, также подходит для обработки зараженных поверхностей. Порошок смешивают с водой в пропорции 1:5, так же, как и в случае с медным купоросом, применяя средства защиты.
Для противников народных методов были разработаны специальные фунгициды, позволяющие решить проблему грибка на окнах из пластика. К ним относятся:
- Vincents Polyline;
- «Белизна»;
- «Текс»;
- «Доместос»;
- «Dufa».
Для обработки чувствительных к агрессивным препаратам пластика и стеклопакетов используют щадящие средства. Это может быть раствор на основе уксуса и борной кислоты (200 млх200 мл), а также 3% раствор перекиси водорода.

Подходящий вариант — средства, предназначенные для деликатной дезинфекции поверхностей из пластика и керамики — Mellerud, Cillit Bang и Tilex, Neomid и «Биоцид». Также обработать окно можно проверенными аптечными противогрибковыми средствами: клотримазолом или «Кандидом».
Приверженцам натуральных препаратов стоит попробовать удалить остатки плесени маслом чайного дерева из расчета чайная ложка на стакан воды или маслом семян грейпфрута.
В заключение отметим, что только комплексный подход к решению проблемы плесени на пластиковых окнах даст стойкий результат.
